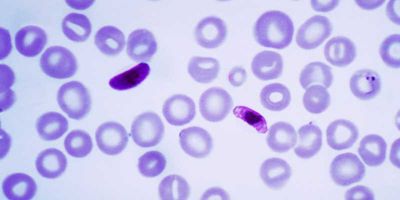
New malaria parasite beats best known drugs against disease

Latest News
latest
- Euro Cranes Celebrates Ugandan Diaspora Unity Through Sport
- Masaka Road Corridor Gets Power Boost After UEDCL Upgrade
- Uganda Prisons Establishes Farmer Field Schools to Improve Agricultural Skills
- MOFPED, URA Agree on Target of 20% Tax-to-GDP Ratio by FY 2029/30
- IGG Calls for Collective Action To Improve Uganda CPI Ranking
- IGG Arrests Parliament Officials Over Corruption-Related Charges
- Gen. Muhoozi Meets NMG Owners Over NTV Uganda, Daily Monitor Closure
- Uganda Secures 481 Billion Ugx Financing for Kitgum–Kidepo Road
- Finance Minister Launches World Bank-Uganda Partnership Framework and Public Finance Review
- Government Launches Online Recruitment for District Jobs to Eliminate Corruption
- Retirement Benefits Sector Key to Uganda's Growth Target – Hon. Musasizi
- Museveni Passes Out Nearly 10,000 Officers, Urges Discipline and Integrity